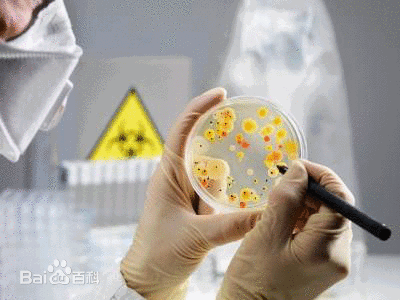

痰标本留取的正确打开方式
在鉴定下呼吸道感染病原体时,痰液是送检最多也是最好取材的标本,但也是最受争议的微生物学标本,因为其容易受到上呼吸病定植和污染菌原微生物的影响,造成其下呼吸道病原菌诊断价值有限。

现阶段几乎所有呼吸科病人都需要留痰,凡有痰液的下呼吸道感染患者均可留痰进行涂片和培养。痰标本可用于普通细菌、真菌及分枝杆菌的培养检测,但不适用于检测厌氧菌。因为引起下呼吸道感染的厌氧菌多为条件致病菌,而口咽部有大量厌氧菌定植,如果痰厌氧菌培养,那么不可避免分不清敌友,所以采集彻底避免上呼吸道菌群污染的标本才是准确建立厌氧菌感染病原学诊断的关键。而普通的咳痰、经口咽部活支气管镜活人工气道的下呼吸道吸引物甚至是普通支气管肺泡灌洗液,均适用于厌氧菌检验。
由于人体咽喉以上呼吸道黏膜表面及其分泌物含有众多微生物,唾液含菌量也非常多,老年、重症或住院病人的上呼吸道定植致病菌更多,致使途径口咽部的咳痰经常受到污染,影响结果判定。痰标本质量的好坏,或者是否能避开上呼吸道菌群污染而采集下呼吸道感染部位的标本,直接影响病原学诊断的准确性和可靠性。由于咳痰非常容易受到口咽部定植菌污染,分离到的细菌往往不能真正代表下呼吸道感染的病原菌,为减少污染,痰培养前需要做标本质量评估,革兰染色进行细胞学判断是一种较为可靠的方法评价标本是否来自于下呼吸道的方法。那么怎么合格留取合格的痰液标本进行科学的需要微生物检验呢?
这是非常重要的步骤,而绝大多数时候都是容易被我们忽略的步骤。根据卫生部发布的WS/T 499-2017 下呼吸道感染细菌培养操作指南和WS/T640-2018 临床微生物学检验标本的采集和转运指南,不难发现对于下呼吸道标本的采集,需要特别注意防止口腔菌群的污染。正确的留取方式是(1)抗生素使用前采集,若患者有假牙,应摘掉牙托,清洁口腔(刷牙或用清水漱口),深部咳出痰液,留取到无菌杯中,若多为口水需要重新留取;(2)留痰时,应在医护人员陪同下采集。(3)痰标本采集后1-2h内必须送检,因为室温下2h会降低肺炎链球菌、流感嗜血杆菌等苛养菌的分离率,而定植于上呼吸道的非致病菌以及许多条件致病菌,如铜绿假单胞菌可过度生长。(4)普通肺炎的话,可每天送检一次痰标本,连续2-3天。

总的来说,合格的痰对于明确下呼吸道感染病原菌诊断具有很重要的意义,特别是社区获得性肺炎患者和结核患者的诊断,因此,科学留取合格的标本是诊断的第一步。
上一篇: 最亲密的朋友---脂肪
下一篇: 钙、铁到底有什么作用?




























 版权所有© 国药东风总医院
版权所有© 国药东风总医院  鄂公网安备 42030302000164号
鄂公网安备 42030302000164号